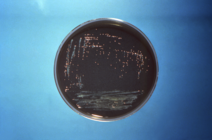
Blue and black Petri dish with Legionella culture

Look Out for Legionnaires' Disease: 2025 Legionellosis Testing and Public Health Recommendations
This bulletin is being sent to local public health officers and nurses, Tribal health directors, infection preventionists, long-term care facilities, Wisconsin National Healthcare Safety Network (NHSN) users, and subscribers of the Division of Quality Assurance's Assisted Living Forum and Notifications and Updates lists.
 It’s that time of year again when cases begin to increase in Wisconsin. During the warmer summer months, people are more likely to be exposed to Legionella bacteria in aerosolized water droplets. Water droplets can aerosolize from showers and other fixtures served by the hot water distribution system, cooling towers (parts of large air conditioning systems), decorative fountains, hot tubs, and other human-made water systems.
Uncharacteristically, there were more confirmed cases of Legionnaires’ disease this winter and spring compared to previous years in Wisconsin. Compared to an average of approximately 40 reported cases from January through May in 2020–2024, 67 cases were reported in 2025. This is approximate 50% increase in reported cases.
We need your help in diagnosing and reporting cases of Legionnaires' disease to promptly identify sources of exposure to Legionella so that we can prevent further infections.
Legionnaires' disease testing
There are a number of considerations when determining who should be tested for Legionnaires’ disease. Does the patient have pneumonia? Have they traveled recently? Have they had a recent potential exposure? You can find a list of situations in which you should test your patients for Legionnaires’ disease by visiting the Department of Health Services (DHS) legionellosis webpage.
When testing for Legionnaires’ disease, order both a Legionella culture and a urinary antigen test. Legionella culture requires collection of sputum or other lower respiratory specimens.
Testing best practices
-
Make sure you’re not missing some species and serogroups. Urinary antigen tests will only detect Legionella pneumophila serogroup 1, resulting in a missed opportunity to diagnose approximately 20% of all Legionnaires’ disease cases if not paired with either a Legionella culture or Legionella PCR test.
-
Don’t throw out lower respiratory specimens. Laboratories should not discard the sputum after a routine sputum culture for pneumonia if a Legionella culture has not been ordered, even if the patient has a positive urinary antigen test.
- Additionally, laboratories should not reject lower respiratory specimens for Legionella culture based on lack of white blood cells in the sample or contamination with other bacteria in the sample. Legionella can often be recovered on selective media.
-
Send sputum to the Wisconsin State Laboratory of Hygiene (WSLH) for free culture testing. Legionella will not grow on standard media used for routine respiratory cultures. A Legionella culture must be specifically ordered. See instructions for laboratories on how to ship specimens to WSLH.
- DHS approval is not needed for Legionella culture testing for patients with positive urine antigen tests
- Urine is not a validated specimen for Legionella culture testing and will be rejected if sent.
-
Help us find the source of exposure. Isolates obtained from Legionella culture are very helpful in comparing patients to Legionella isolates from environmental samples. This comparison is only possible if sputum or lower respiratory specimens are collected, Legionella culture is ordered, and isolates are sent to WSLH.
|
Report cases as soon possible
Health care facility managers: You can prevent healthcare-associated Legionnaires’ disease!

Legionnaires' disease can be prevented by minimizing growth of Legionella bacteria in building water systems. One of the most effective ways to prevent healthcare-associated Legionnaires’ disease is to implement a water management program compliant with American Society of Heating, Refrigerating, and Air Conditioning Engineers (ASHRAE) Standard 188.
The Centers for Medicare & Medicaid Services requires hospitals and long-term care facilities to implement a water management program that meets industry standard. Some other settings are also recommended to develop a water management program. Use this short worksheet to assess the needs for a water management program in your facility.
The Centers for Disease Control and Prevention (CDC) offers a toolkit to assist with developing a water management program. For facilities that currently have a water management program, consider using the Council of State and Territorial Epidemiologists’s (CSTE) Water Management Program Evaluation Tool to perform a gap analysis on the current program and identify potential areas for improvement.
Find additional resources such as toolkits, trainings, templates, fact sheets, FAQs, and special considerations on Legionnaires’ disease for facility managers on the DHS legionellosis webpage.
|
Resources

-
DHS Legionellosis webpage: Detailed recommendations for health care providers, laboratorians, local and Tribal public health departments, and health care facility managers.
-
Diagnosing Legionnaires’ Disease: Best Practices, P-02433: One-page factsheet on diagnostic best practices.
- Resources to help health care facility managers implement an effective water management program to prevent cases of healthcare-associated Legionnaires’ disease:
Thank you so much for your help preventing, diagnosing, and reporting Legionnaires' disease.
|
|